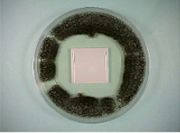
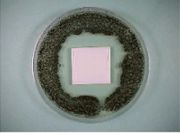
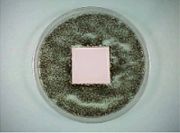
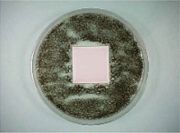
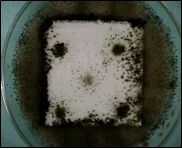

Antifungus (CAVINON®)
Inorganic/Organic hybrid Anti-mold Agent CAVINON®
CAVINON® is an organic/inorganic hybrid anti-mold of which anti-mold component is intercalated in an inorganic layered compound. CAVINON® has features such as heat resistance, water resistance, and sustainability which are difficult to obtain with conventional organic anti-mold agents. It can be used in a variety of applications where durability is required.
Characteristics
Features
- Able to be molded into resin due to its high heat resistance.
- Designed to release active ingredient gradually and keeps long lasting effect.
- Resistant to water and chemical.
- Effective against wide range of molds.

Specification
Grade and characteristics
| Grade | Characteristic | Appearance | Average particle size | Heat resistance |
|---|---|---|---|---|
| CAVINON® 800 | Standard | White ⁓ pale yellow | 5 μm | Approx. 250℃ |
| CAVINON® 900 | Anti-mold + Anti-bacteria | White | 4 μm | Approx. 270℃ |
| CAVINON® 740HV | For plastic | White ⁓ pale yellow | 5 μm | Approx. 250℃ |
| CAVINON® 940 | For sealant, paint | Pale yellow | 4 μm | Approx. 230℃ |
Mechanism
CAVINON® exhibits its anti-mold effect by gradually releasing an active ingredient, causing functional inhibition inside mold cells and eliminating the regeneration of fungal cells.
Anti-mold effect
CAVINON® shows anti-mold effect against a wide range of microorganisms.
Minimum inhibitory concentration[MIC](μg/mL)
| Microorganisms species | CAVINON® 800 | CAVINON® 900 | CAVINON® 740HV | CAVINON® 940 |
|---|---|---|---|---|
| Aspergillus niger | < 6.25 | < 6.25 | < 6.25 | < 6.25 |
| Chaetomium globosum | < 6.25 | < 6.25 | < 6.25 | < 6.25 |
| Penicillium funiculosum | < 6.25 | < 6.25 | < 6.25 | < 6.25 |
| Penicillium citrinum | < 6.25 | < 6.25 | < 6.25 | < 6.25 |
| Cladosporium cladosporioides | < 6.25 | < 6.25 | < 6.25 | < 6.25 |
| Aureobasidium pullulans | 6.25 | 12.5 | 6.25 | 12.5 |
| Gliobasidium virens | 50 | 100 | 100 | 25 |
| Rhizopus oryzae | 100 | 200 | 100 | 200 |
| Escharichia coli | 2000 | 500 | 250 | 500 |
| Staphylococcus aureus | 62.5 | 125 | 62.5 | 125 |
Safety
The safety of CAVINON® has been confirmed by various tests. There is some skin irritation depending on the grade, but no irritation is observed with the resin product which CAVINON® was mixed at a practical concentration.
| Item | CAVINON® 800 | CAVINON® 900 | CAVINON® 740HV | CAVINON® 940 |
|---|---|---|---|---|
| Acute oral toxicity LD50 | > 2,000 mg/kg | > 2,000 mg/kg | > 2,000 mg/kg | > 2,000 mg/kg |
| Mutagenicity | Negative | Negative | Negative | Negative |
| Primary skin irritation | Moderate irritation | Low irritation | Moderate irritation | Moderate irritation |
| Human patch test | 1.5% PP board No irritation |
– | 0.5% ABS board No irritation |
– |
Applications
Application example
| General goods | Sink strainer, Wash basin, Bathtub cover, Cleaning tools, Bucket |
|---|---|
| Electronic appliances | Air conditioner, Washing machine, Vacuum cleaner, Refrigerator |
| Interior materials | Wallpaper, Curtain, Shower curtain, Carpet |
| Construction materials | Paint, Sealant, Mortar, Concrete, Adhesive |
| Others | Tent, Leather shoes, Sporting goods |
Product performance
Example of application in polyethylene resin
The anti-mold effect lasts for a long time since CAVINON® is difficult to bleed out. (Halo method, Cultivation 7 days)
| Initial | After 90 days | |
|---|---|---|
| 0.5% of CAVINON® 800 | ![]() |
![]() |
| 0.5% of Triazole based anti-mold agent | ![]() |
![]() |
| 0.5% of Haloalkylthio based anti-mold agent | ![]() |
![]() |
Example of application in sealant
The silicone sealant containing CAVINON® exhibits an excellent anti-mold effect even after being immersed in running water for 200 hours. (Method B of JIS Z 2911 for plastics)
| Initial | After 200 h in running water | |
|---|---|---|
| Blank | ![]() |
![]() |
| 1.0% of CAVINON® 940 | ![]() |
![]() |
| 1.0% of Isothiazolin based anti-mold agent | ![]() |
![]() |